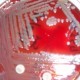

Yearly Archives: 2016
MHOA Shares Healthy Tips
As part of its commitment to enhance children’s well-being through programs and initiatives that encourage active, playful creativity, the McDonald’s Hispanic Owner Operator’s Association (MHOA) joined the National Museum of… Read more
Why Are Insulin Costs Skyrocketing Across the United States?
The cost of insulin in the United States has almost tripled for certain diabetes patients during the last five years, according to a new research letter published in the Journal… Read more
‘Covering All Kids’ Passes House, Moves to Illinois Senate
On April 18th, Illinois House Speaker Michael Madigan, “Covering All Kids” bill sponsor Representative Lisa Hernandez, Department of Healthcare and Family Services Director Felicia Norwood, Minority leaders Jim Durkin and… Read more
Cluster of Elizabethkingia Cases Identified In Illinois
The Illinois Department of Public Health (IDPH) announced recent test results show ten Illinois residents have been diagnosed with infections caused by a strain of Elizabethkingia anophelis that is different… Read more
“Waddle It Be?” Shedd Aquarium Teams Up with Lurie Children’s Hospital to Name Penguin
Curious, playful and coming into his own, Shedd Aquarium’s rockhopper penguin chick that was no more than a ball of fluff only 10 months ago is now fully-grown and ready… Read more
RTA Encourages Commuters to Celebrate Earth Day
The Regional Transportation Authority (RTA), along with the Chicago Transit Authority, Metra and Pace, are encouraging everyone to celebrate Earth Day this year by riding the region’s transit system and… Read more
Local Officials Call on Dept. of Aviation Commissioner Evans to Ensure Reinstatement of O’Hare Workers
This week, SEIU Local 1, Alderman Susan Sadlowski Garza (10), Alderman Nicholas Sposato (38), Alderman Anthony Napolitano (41), and Alderman Carlos Ramirez-Rosa (35) called on Department of Aviation Commissioner Ginger… Read more
Illinois Senate Approves Bill to Remove Criminal Penalties for Marijuana Possession
The Illinois Senate approved a bill 40-14 on Tuesday that would replace criminal penalties with a civil fine for possession of a personal amount of marijuana. It will now go… Read more
Illinois Lottery Unveils New Scratch-Off Game
On Monday, April 18th the Illinois Lottery unveiled a new scratch-off game aimed at Latinos called lotería, in honor of the Mexican board game, at the Mexican Arts Museum. Attendees… Read more
Illinois Warrior Assistance Program Launches “530 by 5/30” Campaign
The Illinois Warrior Assistance Program has launched a campaign to help veterans and their families across the state of Illinois, who need help with the emotional, medical or legal challenges… Read more